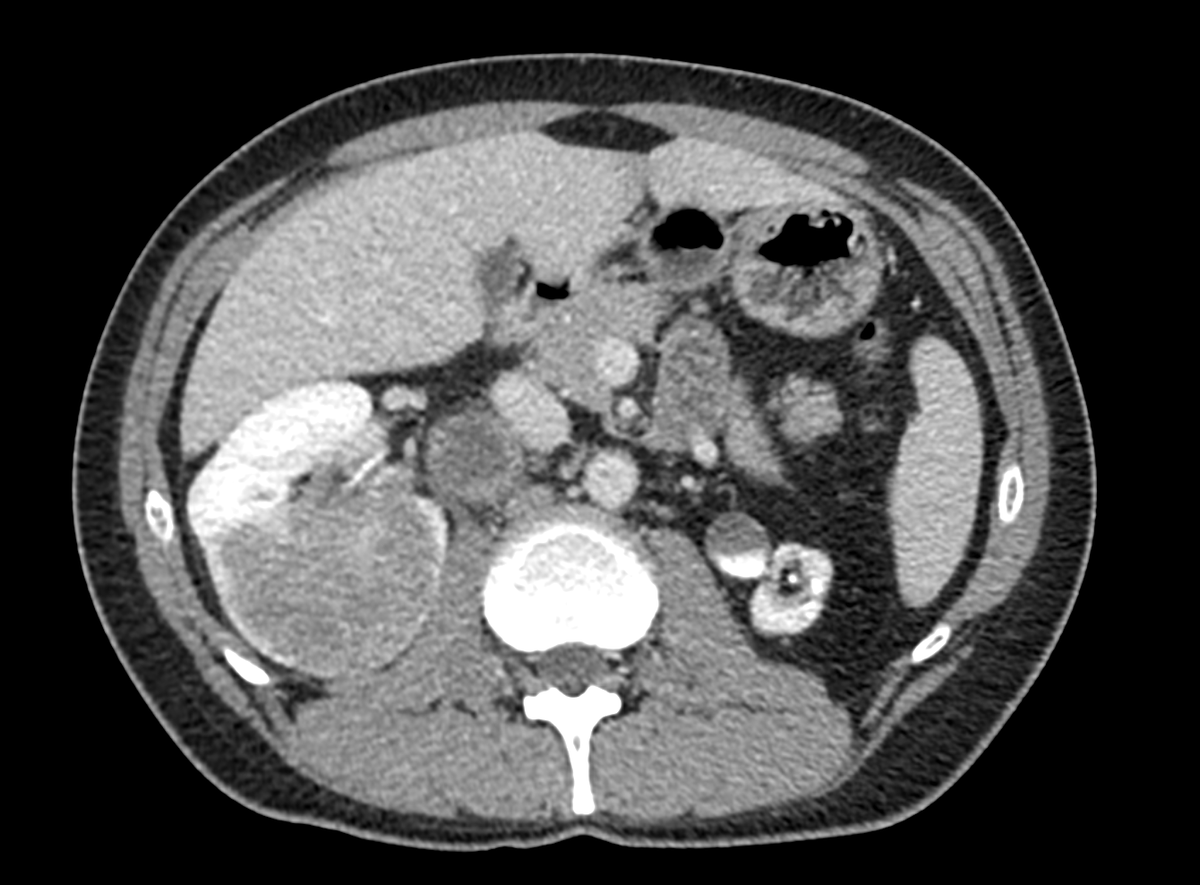
Umberto Capitanio tweet media

Mike Risk
107 posts


@UMNUrology @wiscurology @NakadaSteve @hanhan_li @VAMinneapolis @You_the_Mann @C2UroDoc @albersheim @VishnuIyer96 @EBMUrology Also thanks for the great gifts and cards!

English

Today we said farewell to our faculty friend and colleague @mchlrisk who is leaving for @wiscurology; what a catch for them @NakadaSteve. We will miss him. Tremendous thanks to @hanhan_li for hosting @VAMinneapolis @You_the_Mann @C2UroDoc @albersheim @VishnuIyer96 @EBMUrology


English

@UMNUrology @wiscurology @NakadaSteve @hanhan_li @VAMinneapolis @You_the_Mann @C2UroDoc @albersheim @VishnuIyer96 @EBMUrology Thanks to Dr Li for hosting and everyone who came out to make it a touching (and little tearful) goodbye. The wonderful faculty, residents and staff make @UMNUrology and @VAMinneapolis such an outstanding place to work. Will all be sorely missed.
English

@u_capitanio @Uroweb @aleantonellibs1 @minerviniandre @UroOncMD @alexmottrie @JamesPorterMD @AndreaNecchi @_alelarcher @EAUYAUrology @EAU_Uroonco What are people using as neoadjuvant for these cases if CCRCC? I have someone in similar situation.
English

48 years old. 6 cm completely endophytic right kidney mass. Hilar cN1 4 cm. Atrophic left kidney. No symptom, no comorbidity. What to do? #robotics #open #partial #nephrectomy #LND #neoadjuvant #biopsy ???

English
Mike Risk retweetledi

When you try to take the instruments from the resident twitter.com/buitengebieden…
English

UroTwitter poll: Is your center doing pre-op COVID testing for all?@daviesbj @wandering_gu @dr_coops @mdallera @uretericbud
English

@alexsalvinews When they were arrested outside Mpls (Brooklyn Park, Maple Grove PDs) are they even related to the protests/riots? Sig # were.
English

@EricKleinMD Jordan, though have to state COI as I am from Chicago. Dr Klein- any COI regarding LeBron?
English

A considered and thoughtful Editorial in NEJM by Albertson et al on PSA screening. Enough fodder for both sides I suppose. A must uro read (HT @benristau)
nejm.org/doi/pdf/10.105…
English
Mike Risk retweetledi
Mike Risk retweetledi

@uretericbud @dytcmd @gorejohn @jimhumd @jessicakutikov Looks great! Now need to see what happened on prior practice models. Personally went to buzz cut last night 😐
English

@dytcmd @gorejohn @jimhumd Wife saw tweet. Demanded I post pic (AFTER she touched it up a bit more). (🤫this is from a good angle). 🤣 @jessicakutikov, always grateful to your many many talents!

English
Mike Risk retweetledi

Last month's hastily scribbled idea for an editorial on society's increased awareness of vaginas is seeming quite frivolous right now 😒
Nette Fenner@NetteFenner
I can't believe that only a few weeks ago we were talking about Gwyneth Paltrow's vagina candle
English









